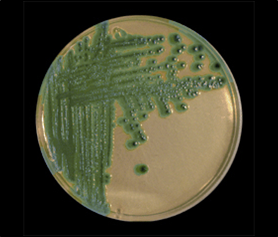
Salmonella abony

AGAR CROMOGENICO SALMONELLA CHROMOSALM, APROBADO EN ISO 6579 COMO ABC AGAR. A DIFERENCIA DE LOS MAGENTA-GAL, ES MÁS SENSIBLE Y ESPECÍFICO
MICROKIT® ABC CHROMOSALM AGAR
Medio cromogénico para Salmonella (Investigación de la Beta-Galactosidasa )
(UNE 34-554:1983, UNE 34-818:1985, EN-12824:1997, UNE-EN ISO 6579:2003)
INTRODUCCIÓN
Presentamos el esperado medio cromogénico de MICROKIT para aislar colonias del género Salmonella de forma diferencial y específica. Totalmente diferente a los medios cromogénicos de Salmonella de otras marcas, que tienen cromógenos color rojizo mucho menos específicos.

Colonias verdes: Salmonella. Colonias negras: otras Enterobacterias, incluida Citrobacter. Colonias incoloras: Proteus
Salmonella puede diferenciarse de otras Enterobacterias gracias a su mecanismo para producir alfa-galactosidasa en ausencia de beta-galactosidasa. MICROKIT® CHROMOSALM incorpora dos sustratos cromogénicos, CHE-Gal y X-alfa-gal, que permiten visualizar esta actividad en la misma placa.
Efectivamente, CHE-Gal es metabolizado por la beta-galactosidasa, produciendo colonias negras en presencia de hierro, como ocurre en la mayoría de Enterobacterias.
X-alfa-gal es hidrolizado por Salmonella produciendo colonias verde-azuladas, claramente distinguibles de las de otras Enterobacterias, negras y de las de otros microorganismos, incoloras. Las reacciones cromogénicas están muy concentradas en las colonias, dejando al medio de su color natural, crema.
El resto del medio está basado en la fórmula DCA de Hynes, utilizando desoxicolato sódico y citrato sódico como inhibidores de la flora acompañante.
TODO TIPO DE SALMONELLAS
Gracias a todo ello, MICROKIT® CHROMOSALM detecta las cepas enterotoxigénicas de Salmonella (S.enteritidis, S.typhimurium, S.paratyphi…) y también detecta S.typhi, en todo tipo de muestras alimentarias, clínicas, agua…
Muchos medios para aislamiento de Salmonella (incluidos muchos otros modernos medios cromogénicos con Magenta-Gal) son poco selectivos y/o diferenciales, provocando un inmenso gasto en confirmaciones de colonias sospechosas que resultan ser negativas (Proteus, Citrobacter…).
Con una asombrosa especificidad (99,7%), MICROKIT® CHROMOSALM reduce drásticamente la necesidad de confirmar falsos positivos, ahorrando trabajo y grandes costes en medios adicionales, galerías bioquímicas y pruebas inmunológicas:
¡Requiere un 95% menos confirmaciones de colonias que los medios tradicionales!. De este modo, su aparente elevado coste de “medio cromogénico” es sólo un espejismo.
Pero además, con frecuencia, en los medios habituales para Salmonella, los crecimientos abundantes de flora acompañante enmascaran a Salmonella cuando está presente en bajas proporciones.
La incidencia de falsos negativos en MICROKIT® CHROMOSALM es también ínfima, ya que la sensibilidad es del 90,5%, obteniéndose un 14% más positivos reales que en los demás medios.
En Enero de 2003, publicación en XIX Congreso SEM Santiago, hemos validado este medio en un estudio intercolaborativo para 250 muestras naturales de todo tipo de alimentos, aguas y manipuladores, con 6 laboratorios participantes…
…resultando la mayor sensibilidad (del 89,47%), especificidad (del 98,45 %) y eficiencia (del 96,40 %) de todos los medios de aislamiento selectivo de Salmonella, con gran diferencia respecto a todos ellos.
COMPOSICIÓN (BASE Desoxicolato Citrato Agar)
Extracto de buey 5,00 g/l
Peptonas 5,00 g/l
Citrato Sódico 8,50 g/l
Desoxicolato Sódico 5,00 g/l
Citrato Férrico Amónico 0,50 g/l
IPTG 0,03 g/l
Mezcla Cromogénica 0,38 g/l
Agar-agar 12,00 g/l
pH final 7’2 ± 0’2
.
MODO DE EMPLEO
Disolver 36’5 gramos de medio MICROKIT® CHROMOSALM en 1 litro de agua bidestilada a temperatura ambiente (ideal 21-25 ºC). Dejar embeber 10 minutos, calentar hasta ebullición, agitando hasta la total homogeneización.
Esterilizar manteniendo la ebullición durante 1 minuto. No autoclavar. No sobrecalentar. Los frascos sólo se pueden refundir una vez.
Enfriar rápidamente a 47 ºC y dispensar en placas Petri.
Una vez preparadas, las placas pueden mantenerse una semana a 2-8 ºC, en la oscuridad, precintadas para evitar su desecación.
Sembrar en estría las muestras clínicas procedentes de caldo Selenito, y las muestras alimentarias procedentes de los medios de pre-enriquecimiento más enriquecimiento habituales (ver ISO 6579 de Salmonella).
Incubar 18-24 horas a 37 ºC aproximadamente.
LECTURA DE RESULTADOS 24–48 h a aprox. 37°C
- S. typhimurium MKTN 12190 Colonias verde-azuladas. Recuperación 96,3-200% con respecto a TSA estandarizado (El que cumple con recuperación superior al 92-125% con respecto a cepas cuantitativas internacionales, trazables a la cepa tipo).
- Salmonella abony MKTN 6016 Colonias verde-azuladas (alguna cepa, si es beta-galactosidasa positiva, puede crecer con colonias negras o incoloras *). Tamaño 1-2 mm.
- E.coli MKTA 25922: Colonias negras (o no crece)
- Shigella flexneri MKTA 12022: Colonias incoloras (alguna cepa, si es beta-galactosidasa positiva, puede crecer con colonias negras). Tamaño 1-2 mm.
- Citrobacter freundii MKTA 8090: Colonias negras.
- Proteus mirabilis MKTA 14153: Colonias incoloras o verde claro con olor a pescado. Tamaño 0,5-2 mm.
- Klebsiella oxytoca MKTA 13182: Colonias negras, mucosas. Tamaño 1-2,5 mm.
- Pseudomonas aeruginosa MKTA 9027: Colonias incoloras o verdes fosforescentes. Tamaño 0,5-1 mm.
BIBLIOGRAFÍA
- Perry, J.D., Ford, M., Taylor, J., Jones, A., Freeman, R., Gould F.K. 1999. A New Chromogenic Agar for selective Isolation of Salmonella spp. J.Clin.Micro. 37: 766-768.
*Salmonella are normally alpha-galactosidase positive (green colonies) but beta-galactosidase negative (not black colonies). In the original publication they tested 556 strains of S.enteriditis and all growth green, that is alpha gal positive. Out of the 1022 Salmonella tested after, only 2 were reported colourless: a Braenderup and a Saintpaul. So, it is possible to get an exception but they are very rare. - Sanchis, J. y otros 11 autores, 1/2003, XIX Congreso SEM Santiago.: Validación del medio CHROMOSALM mediante un estudio intercolaborativo en los más diversos tipos de matrices.
- Sanchis, J. 09-2014: XIX Congreso Nacional de Microbiología de los Alimentos. Doble enriquecimiento simultáneo para detección de Salmonella. J. Sanchís. MICROKIT.
https://www.microkit.es/fichas/CROMOSALM-MICROKIT-AGAR.pdf
PRESENTACIÓN
MICROKIT® CHROMOSALM se comercializa en:
* Envases 100 g ( para unos 3 litros de medio final), ref: DMT500-. 500 g ref: DMT500
* Frascos hidratados y estériles, para fundir, de 100 ml, ref: RPL012.
* Tubos preparados 15 ml para elaborar una placa, ref: TPL402.
* Placas preparadas 25 ml (3 meses de caducidad), ref: PPLM55
AGAR CROMOGENICO SALMONELLA CHROMOSALM, APROBADO EN ISO 6579 COMO ABC AGAR. A DIFERENCIA DE LOS MAGENTA-GAL, ES MÁS SENSIBLE Y ESPECÍFICO
ATENCIÓN, MÉTODO RÁPIDO PARA SALMONELLA (SALMOQUICK):
Uniendo este avance a un enriquecimiento mixto acelerado (mezclando los medios del preenriquecimiento revitalizador y neutralizante:
225 ml Buffered Peptone Neutralizing Water de MICROKIT DMT011+
enriquecimiento selectivo 18 ml SS Broth concentrado [x5] de MICROKIT DMT067)
e incubándolos juntos en las 18 h previas;
permite la detección fiable de Salmonella en sólo 36 h desde la muestra inicial.
Por todo ello, este método acortado es la herramienta que estaban esperando todas las fábricas de productos alimenticios para poder liberar lotes gracias a la detección precoz de este patógeno, que les retrasaba hasta ahora el resultado global del laboratorio microbiológico a 3-5 días.
Sin necesidad de técnicas alternativas indirectas y costosas, que además requieren aparatos lectores especiales
https://www.microkit.es/pdf/Salmoquick-2016.pdf
El usuario es el único responsable de la eliminación de los microorganismos según la legislación medioambiental vigente. Autoclavar antes de desechar a la basura.
Si desea más información sobre nuestros MEDIO MICROKIT® CHROMOSALM AGAR rellene nuestro formulario de contacto http://www.medioscultivo.com/contacto . O si lo prefiere póngase en contacto con nosotros a través de nuestro correo electrónico microkit@microkit.es o por teléfono en el nº 91-897 46 16
https://www.microkit.es/monograficos/5-Salmonella-y-Shigella-monograf–a.pdf